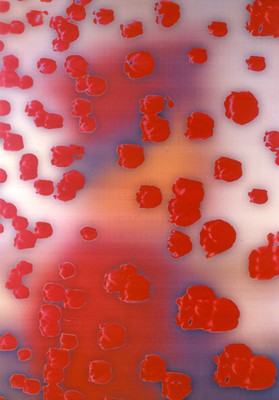

Áthatások
A festészet és az elektrográfia kölcsönhatásairól hat festő munkái kapcsán
A kortárs (magyar) képző- és iparművészetben, valamint az irodalom területén is széles körben megfigyelhető, hogy az alkotók művészeti példáért illetve inspirációért a múltba nyúlnak vissza. Eddigi munkám során főként ezeket, a jelenkori művészetben jelenlévő archaizáló tendenciákat kutattam. Most azonban némiképp fordított szemszögből vizsgálódom. A kilencvenes években, amikor kikiáltották a „táblakép halálának” korát, és egyre nagyobb teret hódítottak a hagyományos festészeti és grafikai eljárásokat részben vagy teljesen kiküszöbölő technikai és műfaji megoldások (például a komputertechnika vagy az installáció műfaja), jószerével az is archaizálásnak számított, ha valaki tradicionális eszközökkel, a táblakép műfajában alkotott. A táblakép (műfaji) válságából következett tulajdonképpen a festészet (technikai) válsága. De az is igaz, ha valaki valamely hagyományos technikai vagy műfaji megoldást választ, még nem szükségszerű, hogy archaizáló tendenciát képvisel.
Az új médiumok, és elsősorban az elektrográfiai eljárások, önálló műfajjá válása után csak egy időre szorultak háttérbe a hagyományos festészeti eljárással készülő művek, például a táblaképek. Megszűnni soha nem szűntek, több alkotó is ragaszkodott ezekhez a tradicionális eljárásokhoz. Azok, akik belekóstoltak az újabb műfajokba, de mellette festettek is, akár akarták, akár nem, de festészetükben valamiképp megjelent a kor legújabb médiumainak, az elektrográfiai módszereknek a hatása. Ez nem véletlen, hiszen az elektrográfia vizuális világa titokzatos, izgalmas és igen gazdag, de műfajilag is sokrétű. Hiszen az elektronikus eszközökkel (és kizárólag azzal) készült képzőművészeti alkotások mind ide sorolhatók, a médium lehet számítógép, fénymásoló vagy fax is. Az eltérő eszközök használata más-más képi megoldást eredményez, de az ugyanazzal a módszerrel készült művek között sincs két azonos. Ezek a különbözőségek nem csupán az alkotók szemléletbeli pluralizmusából fakadnak, hanem az egyes elektronikus eszközök által kínált sokféle lehetőséget is jelzik.
A jelenlegi tanulmány a Magyar Elektrográfiai Társaság által kezdeményezett Digitális hatások a magyar kortárs művészetben című kiállítás-sorozathoz kapcsolódó elméleti munkák nyitó darabja, amely a legújabb médiumok, elsősorban a különböző elektrográfiai eljárások (számítógép, fénymásoló, fax) és a hagyományos képzőművészeti műfajok kölcsönhatásait, áthatásait mutatja be. Miközben ugyanis a modern kor képzőművészeti eljárásai alapnak és etalonnak tekintik a klasszikus műfajokat, és folyamatosan reflektálnak rájuk, illetve továbbgondolják az általuk felvetett művészeti problémákat, addig a mára már önálló műfajjá előlépett legkorszerűbb eszközök szintén hatással vannak a hagyományos alkotások képi világára. Ez a hatás kölcsönös, és folytonos párbeszédet eredményez a régebbi és az újabb művészeti megoldások között, valamint sokszor egyazon alkotó életművén belül is megfigyelhető.
Tanulmányomban a kortárs festészet képviselői közül mutatok be hat alkotót, akiknek festményei különböző aspektusból, de egyaránt tartalmi kapcsolatban állnak az elektronikus eszközök képi megoldásaival, az elektrográfia izgalmas és műfajilag is sokrétű vizuális világával.
A tartalmi összefüggést szeretném hangsúlyozni, azaz a tárgyalt művészeknél nem csupán felszíni hatásról, pl. nem a számítógép szoftvereivel manipulált képek táblaképre való adaptálásáról van szó.
A címként használt áthatás kifejezés nem csak a régebbi és újabb műfajok közötti kölcsönös kapcsolódásra utal, de egyben jelzi a most bemutatott alkotók festményeinek egyik sajátosságát: a rétegzettséget.
Ezek a rétegek akár konkrétan az egymásra rakódó festéknyomokat, akár átvitt értelemben a különböző kulturális és vizuális tradíciók eltérő aspektusait tekintjük alapvetően meghatározóak a bemutatott festők szempontjából. Technikailag több most említett művész esetében is döntő az egyes rétegek fedéséből és egymáson való átsejléséből adódó faktúraképzés alkalmazása.
Bátai Sándor H. M. 1997
Bátai Sándor (1955) művészetének alapvető témája és metaforája az idő. Az idő megfoghatatlan, felfoghatatlan, lényegében elvont fogalma, de ugyanakkor az idő múlásának egészen konkrét nyomai, amelyeket akár saját bőrén mindenki tapasztalhat. Az idő kettős jellege; határtalan és állandó volta, valamint véges és rejtőzködő, öröktől létező folyamata szüntelen kétséget kelt bennünk, elbizonytalanít, sőt sokszor létezésünk értelmét is megkérdőjelezzük. Az idő végességének legfőbb bizonyítéka saját világunk, fizikai valónk, a körülöttünk lévő évszázados, évezredes vagy milliós kulturális illetve földtörténeti emlékek folyamatos pusztulása. Az 1980-as évek közepén született olajfestményein korunk piktogramjai bizonyos rendszerben: a festő közlésmódjának rendje szerint jelentek meg. Ezek ugyanolyan egyértelműen megérthető jelek, mint annak idején a középkori lovagok pajzsának heraldikai utalásai, vagy az őskori sziklarajzok illetve barlangfestmények mágikus képei. Bátai Sándor értelmezése szerint, a művészet mint magasabb szubsztancia áthidalja a korok, technikák illetve értékrendek korlátait. Egy újabb szakaszt jelentenek az 1990-1993 között készült táblaképei, amelyek alapvető jellegzetessége a mértani formák és a szervesen alakuló felületek kettőssége. Korábbi, 1985-1990 között készült olajfestményein, és a kilencvenes évek közepe óta készülő merített papír-művein a rétegződés a földtörténet korszakaihoz hasonló, abból okuló, annak tanulságait is felhasználó képépítési folyamat. Az egyes rétegek nemcsak egymásra rakódnak, de el is mozdulnak egymáshoz képest, mindig más és más szeletek kerülnek felszínre. A folyamat végén egy spirálisan egymásra épülő rendszer alakul ki a részletekből. A rétegzettség szimbolizálja Bátainál a kultúra időben egymásra rakódó rétegeit is. Ugyanez a felületképzés jellemzi az elektrogrfiai módszereket is felhasználó műveit. A H.M. sorozat képein talált fotókból készített elektrográfiákat, fénymásolóval nagyította-kicsinyítette, kontrasztosabbá tette őket, amíg a fotókból szinte fekete-fehér grafika nem lett. Majd ez alapján festette meg az archaizáló faktúrájú képeket. Ez a sorozat 1997 óta folyamatosan készül, és egy személyes történetet helyez egyetemes kontextusba. A fotóalapú festmények főszereplője valós személy, H. M., aki azonban arctalanná válik, megfakul, eltűnik a képekről – az idő elkoptatja a fényképeket, az emlékek szertefoszlanak. Így végül H. M. arctalanná, orwelli utópiák névtelen hősévé válik. Bárki lehet. Bátai H.M. sorozatának képei az emberi sors, a feledésre ítélt emberi lét szinonimái.
Csurka Eszter képe
Csurka Eszter (1969) 2002 körül készített arcképcsarnoka megrázó erejű. Az ábrázolt torzult fejek maszkszerű megjelenítése magában hordozta az elfedés-feltárás dialektikáját, amely minden álarc sajátja. Egyszerre takarja el valódi énünket és vall, a választott szerep által, arról az alapvető tulajdonságunkról, jellemvonásunkról, amely addig titokban maradt. Ebben az értelemben a maszk, ahogy arra Csurka Eszter képei is utalnak, a metamorfózis eszköze, s egyben a változás és átváltozás metaforája. Abszurd módon ugyanakkor az igazság arca is. Ugyanezt a dualistást fogalmazzák meg nagyobb méretű vásznai is, amelyeken az arcnélküli, illetve arctalanná tett alakok teljesen „kitárulkoznak”, jelképesen feltárják legbensőbb énjüket. A Csurka Eszter által megjelenített fejek hagyományos értelemben nem portrék, hanem lelkiállapotok, érzelmek-érzések, jellemvonások, életkorok egyéniesített, mégis általános karaktereit hordozzák, ezáltal egyetemes arcképeknek tekinthetők.
Azon festményei, ahol printek felületi hatásait használja fel képeinek alapjául, szintén az elfedés-feltárás gondolatpárhoz köthetők (például Cím nélkül, 2006, vászon, olaj, 55×55 cm). A printekkel kiegészülő felületképzés tágítja a képek jelentéstartalmait is. Természetesen festő szemmel közelíti meg a számítógépes effektek alkalmazását, és átfesti, festőibbé teszi a printfragmenseket, a faktúrák csak alapul szolgálnak képein. Legtöbbször csupán a háttérben maradnak ezek a számítógépes effektek, néha azonban egy-egy print-fragmentumot beépít a főtémába (például ellipszisek). Egy másik elektrográfiai eszköz is eszembe jut némely festménye kapcsán, a fénymásoló. Olyan torzulások, elnyújtások jelennek meg egyes képeinek alakjain, amilyet a fénymásolóval lehet elérni, amikor elmozdítjuk a fénymásolóba betett tárgyat. Másrészt a képeken hullámzóan torzuló alakok, bár az üvegen keresztül látott látványból indulnak ki, de a galaktikus utazások során elképzelt dimenziók közötti átjárók vibráló, elmosódó anyagtalanságát is felidézik.
Nagy Gábor György Federico Copy 1998
Nagy Gábor György (1966) nem a festészet felől közelít a műfajok közötti kölcsönhatásokhoz. Hiszen korábbi festészeti indíttatású printjein konkrét
festészeti idézetekből készített átiratokat. Az egyik legelső sorozatán Federico Copy (1998) a reneszánsz mester, Piero della Francesca (1410/20k.-1492) 1465-66 körül festett (Firenze, Uffizi) Federigo da Montefeltre portréját (fatábla, tempera, 47×33 cm) dolgozta fel. Ez a művészettörténeti példázat Nagy Gábor György számára elsősorban a reneszánsz portréfestés, a flamand ismereteken alapuló tájháttér, és a vetett árnyékok nélkül, pusztán önárnyékokkal kidolgozott festészeti megoldások magasiskolája, egyfajta művészeti alaptétel. Ezt a történeti alapművet távolítja Nagy Gábor György a számítógép által homályos folttá, azaz emlékképpé, a vizuális emlékezet egy momentumává teszi. Ugyanakkor Federigo Montefeltre profilképe élénk piros színfoltjai miatt könnyen sokszorosítható (ha tetszik másolható (!), erre utal a sorozat címében lévő „copy”) és ezáltal népszerűsíthető vizuális eszköz. Eszköz, amelynek segítségével az örök festészeti-grafikai problematikát, a fény-árnyékhatást, illetve a szín és formaproblémákat éppúgy vizsgálni lehet, mint a sokszorosítás által kommersszé tett művek lélektanát. Hiszen ebből a szempontból válik az élénk vörös szín alapvető jelentőségűvé, amelyet virágszirmokra emlékeztető foltokká bont, s ezáltal is emlékké távolít. Ez a sorozat egyrészt az új médiummal hagyományos technikai és módszerbeli kérdésekre keresi a választ. Másrészt a Federico Copy sorozat a régit felhasználó, újszerűen eredeti alkotás, amely éppúgy rámutat a számítógépes képalkotás újfajta lehetőségeire, mint a sokszorosítás (és ezáltal minden szeriális technika) legfőbb veszélyére: a művészet kommersz kiüresítésére. Következő ide tartozó sorozatán Morandi Copy (2000) Giorgio Morandi művészete előtt tiszteleg. Itt már nem használ konkrét Morandi képekből származó idézeteket, nem Morandi műveket ír át. Hanem egyetlen üveget felhasználva, illetve maga által beállított csendéleteket dolgoz fel. Itt is, akárcsak előző sorozatán maximálisan kihasználja az új médium adta lehetőségeket, olyan képi megoldásokat ér el, amit más eszközzel nem lehet. Egyszerre van jelen az éles és a homályos, egyszerre a benne és mögötte érzetét keltő effektusok, és egyéb olyan vizuális „lehetetlenségek”, amit kizárólag csak a komputerrel lehet megvalósítani. A kész művek ibolyás okkeres színeinek sejtelmességét fokozza a hordozóanyag (amire a nyomat készült) irizáló felülete. Ezek a szín és felületi hatások, illetve a művek tartalmi vonatkozásai (hiszen az üvegek közötti relációk emberi viszonylatrendszereket is modelleznek) egyértelmű asszociációként idézik fel Morandi művészetének szellemiségét, illetve következetes művészi magatartását és etikai attitűdjét.
Legújabb printjein Nagy Gábor György konkrét művekre való utalások nélkül, közvetlen környezetének tárgyai, szegmensei illetve hétköznapi történései által dolgoz fel festészeti problémákat. Így a horizontálisan nyújtott formájú, egyetlen tányért megjelenítő, archaikus festői felületekben bővelkedő printje (2004) anélkül idézi meg akár Leonardo da Vinci Utolsó vacsoráját, hogy erre egyetlen határozott utalást is tenne, sőt, hogy ez célja lett volna. A műfaji határok elmosódását jelzik továbbá azok a festői művek, mint például a 2004-es Várva című komputer print sorozata, ahol visszatérő motívumként van jelen a fény-árnyékhatás, amely jelen esetben a transzparenciával kapcsolódik össze. A korábbi sorozataiban felismerhető klasszikus festészeti idézeteket kiiktatva, ezekben a munkáiban a festészet esszenciális összefoglalását adja. Ezáltal művei a festészeti-grafikai, a sokszorosított-egyedi kategóriáktól megszabadított művészeti teljesítmény szinonimáivá válnak. Mindebből természetesen következik, hogy grafikai tevékenységével párhuzamosan elkezdett maga is festeni. Festményeinek kopottas faktúraképzése szintén a rétegzettségen alapul. A rétegzettség nála is időmetafora. Legújabb festményeinek alapmotívuma a kör (M.A.C.I., 2008, vászon, akril, olaj, 66×66 cm; Simulékony interferencia II. 2008), a tökéletes mértani forma, amely gazdag szimbolikát is hordoz. Többek között a föld, a nap, a hold, a világmindenség, a lélek és teljesség jelképe. Nagy Gábor György képein a kör egyrészt formailag konkrétan utal a korábbi printjein látható tányérokra (Interferenciák I-III., 2008 Alcímek: ¼+1+¼; ½+1+½; 1+1/Búvár), de elsősorban tartalmi jelentése van: az önmagába visszatérő vonal, ami a folytonosság, a tradíciók jelenlétének szinonimája.
Pál Csaba Átlátszó fehér 2004
Pál Csaba (1967) festményei és elektrográfiái párhuzamosan készülnek, és egymással szoros összefüggést mutatnak a kialakuló sorozatok. Festészetében a rétegzettség, az egymást fedő és az egymáson átderengő festéknyomok játsszák a főszerepet.
Pál Csaba vizuális eszközökkel jeleníti meg azt, ami érzékeinkkel fel nem fogható, fogalmainkkal meg nem nevezhető. A mi távlatainkból ezek a dimenziók nem észlelhetők. Ezért Pál Csaba eszközül a ráközelítést, a legkisebb összetevők kinagyítását választja, olyan hatást érve el, mintha apró sejtek mikroszkopikus felvételeit látnánk. Ezzel megerősítve azt is, hogy a lényeg legtöbbször az apró, a megbúvó, a jelentéktelennek tűnő részletekben rejlik. Mindenütt jelen van. Az egész, a teljesség is ezekből a kicsiny részekből épül fel.
Számítógépes munkáiban is a rétegzettség az egyik alapfogalom. Ahogy festményein az egymást fedő és az egymáson átsejlő festéknyomok dominálnak, úgy számítógépes műveiben is a különböző rétegeket helyez egymásra, és azok átfedéseiből, transzparenciájukból, metszeteiből alakítja a kompozíciókat.
Átlátszó fehér (2004) című sorozatának alapját tintasugaras printek képezik, amelyeket fehér színű, vizes alapú festékkel több rétegben átfestett. Ebből születtek a képeken megjelenő különböző árnyalatú szürkék. Az alapnyomat formái elmosódtak, árnyszerű foltokká homályosodtak. A fehér festékre mindig újabb fehér rétegek kerültek. Így meditatív kompozíciók születtek, amelyeken a transzparencia és az elfedés dualitása játssza a főszerepet. Pál Csaba vizuális eszközökkel jeleníti meg azt, ami érzékeinkkel fel nem fogható, fogalmainkkal meg nem nevezhető. A mi távlatainkból ezek a dimenziók nem vagy csak nehezen észlelhetők. A részleges, sejtelmes, opálos elrejtéssel és feltárással az elfedett, a mögöttes, a háttérben megbúvó válik hangsúlyossá képein.
Stark István Hullámok III. 2002
Stark István (1960) festészetében a monokróm képektől indult, amelyek felületét több rétegből építette fel. A faktúra kialakításához mikroméretű üveggyöngyöket is kevert a festékalapba, amely fényjátékot eredményezett a képfelszínen. Ezután egyre behatóbban kezdett a fénnyel foglalkozni. A fény fizikai tulajdonságait, a hullámok természetét vizsgálja. Ezeket a tudományos ismereteit tudatosan alkalmazza műveiben. A tudományos és technikai érdeklődés vezette el a számítógéphez – elektrográfiákat is készít vele, illetve festményeinél azok tervezéséhez használja. A komputerrel megszerkesztett sablonok alapján hagyományos festészeti eljárással készíti képeit (például A hullámok természete III. 2002). A képfelületeket parabolaív-szegmensnek megfelelő görbületben hajlítja. Pontosan kiszerkeszti annak fókuszpontját, ahonnan a legideálisabb a fény visszaverődése. Ahogy elhaladunk a kép előtt, vagy közeledünk-távolodunk, úgy változik a fény beesési szöge, ami optikai játékot eredményez. Az összhatást színtani ismereteivel még tovább fokozza – szimultán kontrasztot alkalmaz a színek kiválasztásában. Stark István festményein a mátrixban elrendezett apró körökből vagy téglalapokból felépülő kompozíciók vibrálnak, hullámzanak mozgásunktól függően maguk is elmozdulnak.
Várady Róbert Cyber I. 2002
Várady Róbert (1950) nézőpontokat és ábrázolási rendszereket vegyítő, hálózattá szublimált, a képtér végtelen űrjében lebegő tárgyakat, arcokat megjelenítő festészetét első megközelítésben úgy interpretálhatjuk, mint a komputer-világ festett párhuzamait. Hiszen a nála megjelenő terek szerkezete és a képcímek (például a többször előforduló ’cyber’ szó) ezt indokolják. De festészeti elemeinek gyökerei egészen az egyiptomi vagy a minószi kultúráig vezethetők vissza. A síkdekoratív háttér, tapétaszerű mintázatán vagy monokróm felületén plasztikusan megjelenő naturalista elemek analógiáit pedig akár a szecesszióban is megtalálhatjuk. Fontosnak tartom ezeknek a történeti előzményeknek a hangsúlyozását, mert úgy gondolom, hogy festészeti szempontból a múltba visszanyúló, abból táplálkozó, s ezáltal archaikus vonásokat hordozó mozzanatok éppoly fontosak nála, mint képeinek filozofikus tartalmai, vagy a legújabb képzőművészeti médiumok (például a számítógép) által alkalmazott módszerek hatása. Az új médium hívei örömmel értelmezték tehát képeit a számítógép festészetre gyakorolt hatásaként (tehát egy fordított műfaji „másolat”-ról is beszélhetnénk). Ugyanakkor Várady Róbert par excellence festő, így művészetének lényegéhez közelebb kerülünk a festészeti eszközök és tradíciók vizsgálata által, mint csupán a felszínes formai hasonlóságok és a tartalmi vonatkozások felől közelítve. Elegendő bizonyíték erre az, hogy Várady Róbert a táblakép (már-már archaikusnak számító) hagyományos műfajában, elsősorban olaj technikával alkot. A komputervilágban használatos cyber szó (mint már említettem) a címadásban ugyan konkrétan is megjelenik, de ezeknek a szintén hagyományos technikával készült festményeknek (!) a cybertereiben realisztikusan ábrázolt, valós emberalakok illetve -fejek láthatók. A testek között kapcsolatot teremtő utak labirintusszerű kanyargása azonban szintén ókori utalásként értelmezhető. A kezükben pisztolynak látszó tárgyat tartó férfiak és nők (Cyber II.) pandanjaként jelennek meg a Szimulakrumok I. (2003) című képen a videokamerát illetve fényképezőgépet szemük elé emelő, a térben elszórtan megjelenített emberek. Várady festményei kapcsán alapvetően a régi és új médiumok közötti konceptuális kapcsolódásról beszélhetünk. Őt nem az elektrográfiai eszközök technikai megoldásai, hanem a komputer virtuális világa foglalkoztatja. Ebben a világban megszűnnek a téri és időbeli határok és korlátok. Itt minden megtörténhet. Például az ifjú Wittgenstein találkozhat időskori önmagával (és fordítva), valamint a pop-ikonnal Madonnával is, ami ugyanolyan fizikai képtelenség (A fiatal Wittgenstein és az idős Wittgenstein és Madonna az interface-ben, 2006). Tehát a számítógépes képszerkesztéssel párhuzamba állított kép tere, nála minden esetben metafizikussá tágul, azaz a tapasztalat határán túli tartományokba vezet. A képein izolált világokként, látszólag egymástól függetlenül lebegő testekkel mutat rá a nagyobb összefüggésekre, amelyekkel matematikai és filozófiai rendszerek, vagy a kibernetika tudománya is foglalkozik. Várady Róbert labirintusának mélyén az autonóm alkotó személye, a festő rejtőzik. Elrejtőzik a külvilág elől. Előlünk, interpretációs kísérleteinkkel képeinek többrétű jelentésrétegei között botorkáló művészettörténészek és művészeti írók elől. Elrejtőzik ugyan, de nem menekül(het).
Várady Róbert
A fiatal Wittgenstein és az idős Wittgenstein és Madonna az interface-ben 2006
Az általam bemutatott művészek közötti összefüggés másik kulcsszava a folytonosság. Hiszen egyrészt a régi és új műfajok kölcsönhatásából született alkotásaik kapcsolatot teremtenek a múlt és a jelen valamint a jövő között. Másrészt most tárgyalt festményeikben a jövő médiumaiban lévő lehetőségek kiaknázásának szándéka éppúgy benne rejlik, mint a tradicionális műfajok, valamint az archaikus korok örökségének megőrzésére való törekvés.